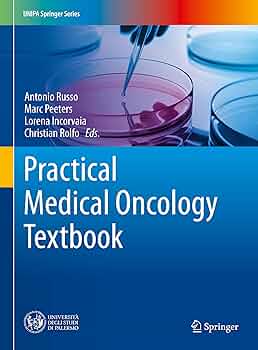
わかりやすい核医学 = Textbook of Clinical Nuclea… Textbook of Clinical Neurology | ScienceDirect

マイストア
変更
お店で受け取る
(送料無料)
配送する
納期目安:
2025.10.26 2:50頃のお届け予定です。
決済方法が、クレジット、代金引換の場合に限ります。その他の決済方法の場合はこちらをご確認ください。
※土・日・祝日の注文の場合や在庫状況によって、商品のお届けにお時間をいただく場合がございます。
わかりやすい核医学 = Textbook of Clinical Nuclea… Textbook of Clinical Neurology | ScienceDirectの詳細情報
Textbook of Clinical Neurology | ScienceDirect。Textbook of Nuclear Medicine: 9780781703031: Medicine。81kw9azO9-L._UF350,350_QL50_.jpg。「わかりやすい核医学 = Textbook of Clinical Nuclear Medicine」玉木長良 / 真鍋 治 / 平田健司定価: ¥ 12000#玉木長良 #真鍋治 #真鍋_治 #平田健司 #本 #自然/医療・薬学・健康新品、未使用です。素人裁断であることをご了承ください。。Clinical Nuclear Medicine: Ahmadzadehfar, Hojjat, Biersack。裁断済みのため全体的に状態が悪いとしております。見る目が変わる! 「欠損歯列」の読み方,「欠損補綴」の設計。医療スタッフ・製造販売業者等のための医療機器安全実践必携ガイド 第7版 全4巻。また、本商品の他にも多数医学書を出品しておりますので、合わせてご検討ください。[美品] ハリソン内科学 第5版 2巻セット 未使用品
ベストセラーランキングです
近くの売り場の商品
カスタマーレビュー
オススメ度 4.9点
現在、2699件のレビューが投稿されています。